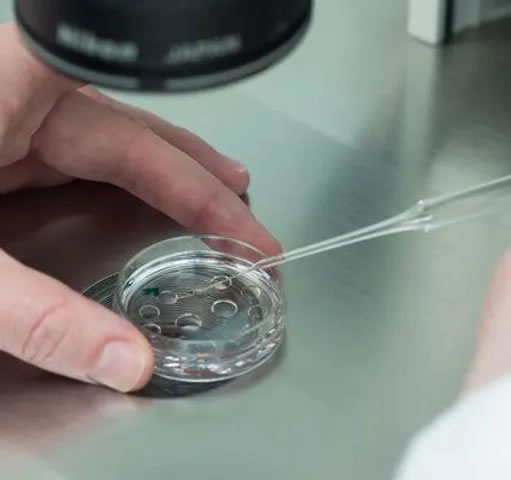

Habilitado para Colombia 
Trabajamos con más de 4 paises.





¿Quienes Somos?
Laurentiembriones es una empresa
que nació en el 2006 dicada a la producción de embriones In Vitro e In Vivo, la empresa desarrolla ambas técnicas
(MOET Y FERTILIZACION IN VITRO) conforme a las necesidades del cliente y del objetivo a alcanzar.
Contamos con un centro de transferencia de embriones habilitado para exportación (COLOMBIA entre los países habilitados)
donde se pueden alojar donantes para la obtención de ovocitos/embriones.
Estamos habilitados para trabajar en Paraguay y Uruguay con el fin de prestar el mismo servicio en ambos países.
Nuestro equipo Multidisciplinario es integrado por profesionales con amplia experiencia y conocimiento en reproducción
que avala un servicio de alta calidad y nivel técnico en diferentes áreas de trabajo.
La empresa cuenta con las habilitaciones y certificaciones correspondientes para dar un servicio de calidad conforme
lo dictan SENASA, SATE Y IETS.

Nuestros pilares
Responsabilidad
Experiencia
Compromiso







